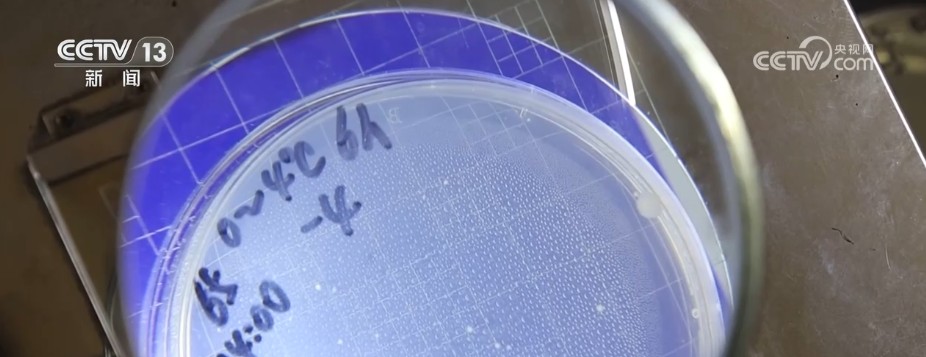

媒体中心
2799.4亿元,增长3.84%!冷链配送需求旺盛 新能源冷藏车成冷链运输“主力军”
2025-10-22
央视网消息:中国物流与采购联合会,8月18日公布冷链物流运行数据。2025年上半年,食品冷链物流业务总需求量为1.92亿吨,同比增长4.35%。
上半年,食品冷链物流服务企业总收入为2799.4亿元,同比增长3.84%。2025年上半年,冷库项目资金投入为223.06亿元,同比增长7.67%。截至6月底,冷库总容量为2.6亿立方米,同比增长6.12%。我国冷链物流运行稳中有升,需求稳步增长,市场规模持续扩大。
新能源冷藏车销量猛增 渐成冷链运输主力
在生鲜电商和连锁餐饮快速发展带动下,冷链配送需求旺盛,轻型冷藏车销量迅速增长。其中,新能源冷藏车悄然成为冷链运输队伍的主力。
2025年上半年,冷藏车销量为29474辆,同比增长18.19%。其中,新能源冷藏车销量为10548辆,同比增长119.61%;新能源冷藏车渗透率为35.8%,同比提高16.5个百分点。
中国物流与采购联合会冷链物流专业委员会副秘书长刘飞介绍,新能源冷藏车渗透率再创新高,这背后得益于从国家到地方对于新能源冷藏车的这个资金补贴的支持,以及在路权方面的进一步的放开。从成本的角度,新能源冷藏车平均成本比传统的燃油车要低5%甚至10%。在效率方面,机动性更高,同时绿色低碳方面的竞争力更强。
菌落数相差数十倍 冷链更好保障生鲜品质
很多药品,以及食品中的生鲜、冻品等都需要进行冷链运输。特别是在炎热的夏季,更要有高效的冷链物流来保证货品的新鲜。同一种生鲜产品是否采用冷链运输会有多大差别?
在这里,检测员将两块鲜肉分别放置于0到4摄氏度、25摄氏度的仪器中。经过4小时后,检测员分别取样进行菌落总数测定。在两块圆形的培养皿上,检测员分别用记号笔标注了菌落的数量。
北京食品科学研究院食品检测员高晓月表示,这个点代表的是菌落总数,这个是14万个菌落,这个是750万个菌落,它两个之间相差50倍。冷藏环境的细菌生长的速度要远远小于常温环境。
放置6个小时的样品测试结果同样佐证了这一结论,即常温环境下的鲜肉样品,菌落的生成数量要远远高于冷藏环境下的数量。
专家表示,要保障食材从生产到消费全链条的安全性,就要充分发挥冷链的恒温控制功能,来保障舌尖上的安全与鲜度。
从产地到终端,从枝头到舌头,整个对于冷链的全程追溯,主要还是通过整个全链条冷链数字化手段的一些升级,以及从我国到地方冷链物流法律法规的一些完善和标准体系的健全。
